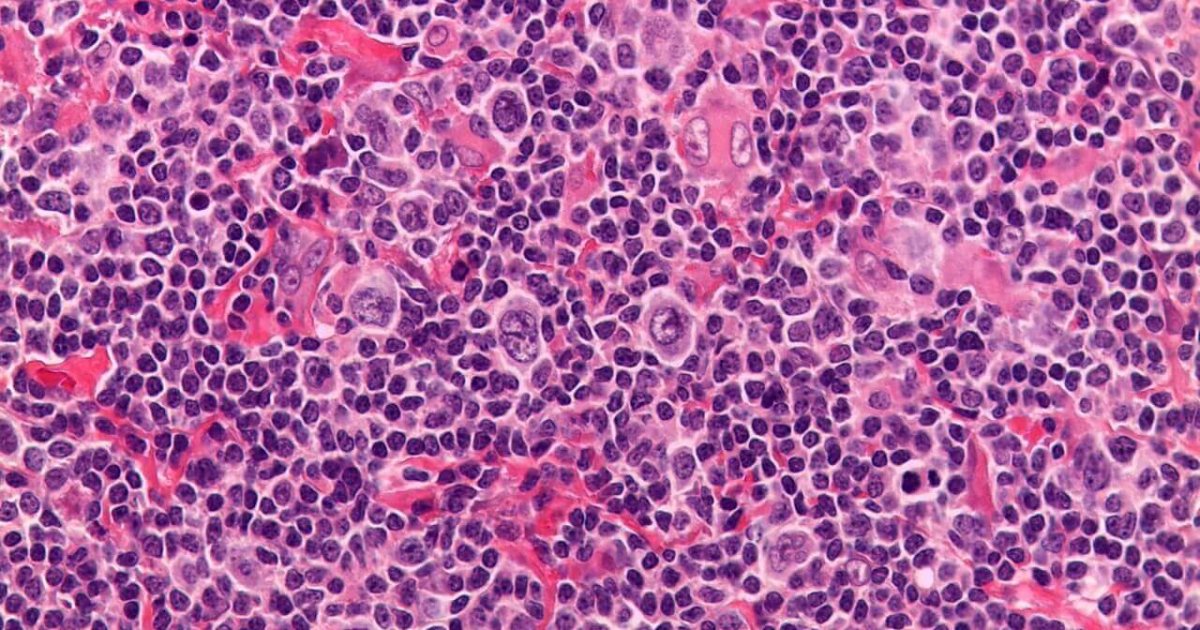
Linfoma de Hodgkin o que é, sintomas e tratamento CUF Linfoma de Hodgkin o que é, sintomas e tratamento CUF

O linfoma de Hodgkin com predomínio linfocítico nodular responde por aproximadamente 5% de todos os LH. O diagnóstico exige confirmação por patologista experimentado, pois no maior estudo já realizado, com 426 pacientes inicialmente incluídos em 17 países da América do Norte e Europa, 49% dos casos foram reclassificados após a.. O linfoma de Hodgkin clássico está subdivido em quatro subtipos: Esclerose nodular. Esse é o tipo mais frequente da doença. Ocorre principalmente em pessoas mais jovens, mas pode ocorrer em pessoas de qualquer idade. Tende a começar nos linfonodos do pescoço ou tórax.

Linfoma De Hodgkin Que Es Y Que Efectos Tiene El Linfoma De Hodgkin Que Sufre Carla Suarez

Liga de Patologia UFC LINFOMA DE HODGKIN

Estudios de imagen para el diagnóstico del linfoma de Hodgkin Ocronos Editorial Científico

Linfoma No Hodgkin PDF Linfoma Linfocitos

Linfoma de Hodgkin o que é, como se prevenir e qual é o tratamento

PPT Linfoma de hodgkin PowerPoint Presentation, free download ID2208965

Nodular sclerosis Hodgkin lymphoma, light micrograph Stock Image C051/0548 Science Photo

Linfoma de Hodgkin el cáncer linfático más común

Agustina Ocampo Patología B 2014 Enfermedad de Hodgkin tipo Esclerosis Nodular
Linfoma de Hodgkin o que é, sintomas e tratamento CUF

PPT Linfoma de Hodgkin Clásico PowerPoint Presentation, free download ID4787861

Linfoma de Hodgkin esclerosante nodular Fitness Life Style Health Club

Linfoma Hodgkin Vídeo Aulas LAPAT YouTube

Linfoma de Hodgkin Concise Medical Knowledge

️ Tratamiento Para El Linfoma Hodgkin En Axila ⚡ InfoAxilas

Liga de Patologia UFC LINFOMA DE HODGKIN

Nodular sclerosis Hodgkin lymphoma (NS HL) cases exhibit characteristic... Download Scientific

O que é Linfoma de Hodgkin Conscientização sobre o câncer

IANCA CONTOU TUDO LINFOMA DE HODGKIN COM ESCLEROSE NODULAR MENSAGEM ESPECIAL YouTube

Futbolista español anuncia que padece linfoma de Hodgkin ¿qué es? UNAM Global
Nos Estados Unidos, cerca de 8.000 novos casos de linfoma de Hodgkin são diagnosticados anualmente, e cerca de 900 pessoas morrem da doença. A proporção homem:mulher é 1,4:1. O linfoma de Hodgkin é raro antes dos 10 anos de idade, sendo mais comum entre 15 e 40 anos de idade; um 2º aumento da incidência ocorre nas pessoas com > 60 anos.. En el linfoma de Hodgkin, los glóbulos blancos, denominados linfocitos, crecen sin control, lo que provoca que los ganglios linfáticos se inflamen y que aparezcan bultos en todo el cuerpo. El linfoma de Hodgkin, que solía denominarse enfermedad de Hodgkin, es una de dos categorías generales de linfoma. La otra es el linfoma no hodgkiniano.